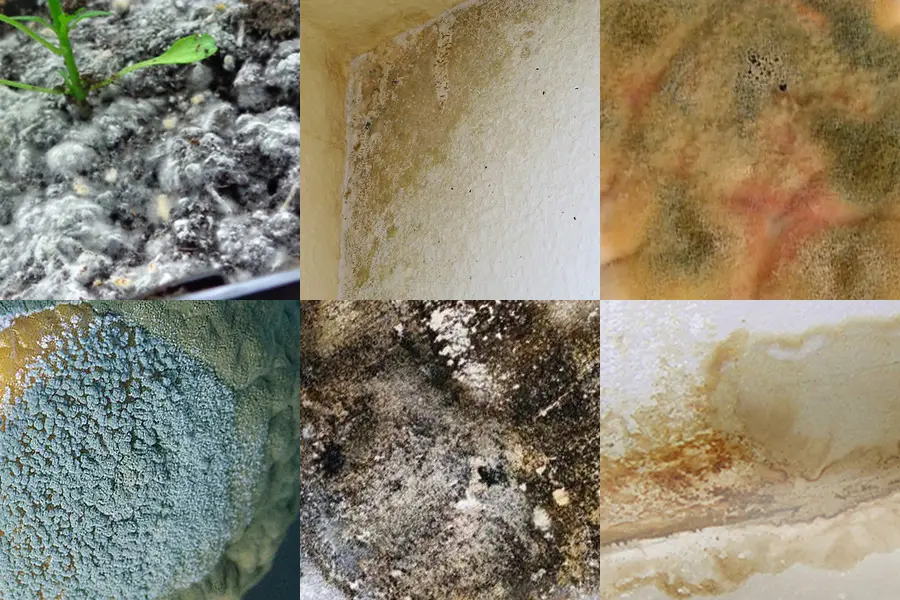
Schimmelentfernung

Manche Reinigungsarbeiten sind nicht alltäglich. Es geht um Situationen, in denen gründliches Arbeiten genauso wichtig ist wie ein ruhiger Umgang mit der Lage. Zur Spezialreinigung zählen unter anderem Tatortreinigungen, stark vernachlässigte Wohnungen, Leichenfundorte oder Brandschäden. Jede dieser Aufgaben bringt eigene Anforderungen mit sich. Deshalb wird vor Beginn genau geschaut, was notwendig ist und wie vorzugehen ist. Gearbeitet wird mit geeigneter Schutzkleidung und unter Beachtung der geltenden Vorschriften. Hygiene und Sicherheit stehen dabei im Vordergrund. Gerade bei belastenden Fällen ist ein sachliches und respektvolles Vorgehen entscheidend. Schritt für Schritt wird die betroffene Fläche gereinigt und in einen ordentlichen Zustand gebracht.
“Wenn Sie unsicher sind, was in Ihrem Fall möglich oder erforderlich ist, sprechen Sie uns an. Wir kommen vorbei, sehen uns die Situation an und besprechen alles Weitere in Ruhe.”
Boppert & Arndt
Spezialreinigung

Nach einem Todesfall oder einem vergleichbaren Ereignis bleibt oft mehr zurück als nur sichtbare Spuren. In solchen Situationen braucht es ein sachliches und diskretes Vorgehen. Tatortreinigungen führen wir unter Einhaltung der geltenden Hygiene- und Sicherheitsvorschriften durch. Dabei arbeiten wir mit geeigneter Schutzkleidung und den notwendigen Maßnahmen zum Infektions- und Arbeitsschutz. Je nach Situation kann es erforderlich sein, nicht nur Oberflächen zu reinigen, sondern auch belastete Materialien zu entfernen. Dazu gehören unter Umständen Bodenbeläge oder einzelne Bauteile. Was notwendig ist, wird vor Ort geprüft und transparent besprochen. Wichtig ist neben der fachlichen Ausführung auch ein respektvoller Umgang mit der Situation. Der betroffene Bereich wird Schritt für Schritt wieder in einen ordentlichen Zustand gebracht. Für dringende Fälle sind wir telefonisch immer erreichbar.
24/7 Hotline: 0179 1246871
Tatortreiniger
Boppert & Arndt
Tatortreinigung

Wird eine Person erst nach einiger Zeit in einer Wohnung gefunden, ist das für alle Beteiligten eine schwierige Situation. Neben der persönlichen Belastung müssen die Räume fachgerecht gereinigt werden. Wir übernehmen diese Arbeiten sachlich und mit dem nötigen Abstand. Nach Freigabe der Wohnung sehen wir uns die Räume an und besprechen vor Ort, was zu tun ist. Je nach Zustand kann es notwendig sein, nicht nur zu reinigen, sondern auch einzelne Materialien zu entfernen. Gearbeitet wird mit entsprechender Schutzkleidung und unter Beachtung der geltenden Vorschriften. Schritt für Schritt werden die betroffenen Bereiche wieder in einen ordentlichen Zustand gebracht. Diskretion ist dabei selbstverständlich. Für dringende Fälle sind wir immer erreichbar.
24/7 Hotline: 0179 1246871
Boppert & Arndt
Leichenfundortreinigung

Nach einem Brand sind häufig nicht nur sichtbare Schäden vorhanden. Ruß, Rauch und feine Partikel setzen sich in Wänden, Decken und Einrichtungsgegenständen fest und können weiterhin belasten. Vor Beginn der Arbeiten verschaffen wir uns einen Überblick über den Zustand der betroffenen Räume. Erst nach Freigabe durch die zuständigen Stellen werden notwendige Maßnahmen eingeleitet. Je nach Ausmaß des Schadens reicht eine Reinigung allein nicht immer aus. In manchen Fällen müssen auch beschädigte oder stark belastete Materialien entfernt werden. Welche Schritte erforderlich sind, wird vor Ort abgestimmt. Bei der Durchführung werden die geltenden Sicherheits- und Hygienerichtlinien beachtet. Ziel ist es, die betroffenen Bereiche wieder in einen ordentlichen und nutzbaren Zustand zu bringen. In vielen Fällen handelt es sich um einen Versicherungsfall. Die erforderlichen Unterlagen für eine Abwicklung können bereitgestellt werden.
Boppert & Arndt
Brandschadenreinigung

In stark verrauchten Wohnungen setzen sich Nikotin und Rückstände mit der Zeit an nahezu allen Oberflächen fest. Fensterrahmen, Heizkörper, Fliesen, Türen oder Einbauten sind häufig sichtbar verfärbt. Wir reinigen diese Bereiche gründlich und Schritt für Schritt. Je nach Belastung reicht eine intensive Reinigung aus. In anderen Fällen kann es notwendig sein, einzelne Materialien wie Tapeten, Paneele oder Bodenbeläge zu entfernen. Vor Beginn verschaffen wir uns einen Überblick und besprechen, welche Maßnahmen sinnvoll sind. Nicht jede Wohnung ist gleich belastet, daher wird das Vorgehen individuell abgestimmt. Ein häufiges Thema bei Raucherwohnungen ist der Geruch. Wenn sich dieser tief in Materialien festgesetzt hat, können zusätzliche Maßnahmen zur Geruchsneutralisation erforderlich sein. Auch hierzu beraten wir im Anschluss. Wenn Sie eine Raucherwohnung reinigen lassen möchten, vereinbaren wir gerne einen Besichtigungstermin.
Boppert & Arndt
Reinigung von Raucherwohnungen

Stark überfüllte Wohnungen sind keine alltägliche Aufgabe. Oft stehen Angehörige oder Eigentümer vor einer Situation, die allein kaum zu bewältigen ist. Wir übernehmen die Beräumung und Reinigung Schritt für Schritt. Vorab wird gemeinsam geklärt, was bleiben soll und was entsorgt werden muss. Wenn ein Betreuer oder Bevollmächtigter beteiligt ist, stimmen wir alles entsprechend ab. Je nach Zustand der Räume können größere Mengen an Gegenständen oder Abfällen vorhanden sein. Die Arbeiten erfolgen mit geeigneter Schutzkleidung und unter Beachtung der notwendigen Sicherheitsmaßnahmen. Am Ende steht eine Wohnung, die wieder übersichtlich und nutzbar ist. Jede Räumung ist anders und wird individuell angegangen. Für eine Besichtigung sprechen Sie uns an.
Boppert & Arndt
Messiewohnung Reinigung

Ein Rohrbruch, eine übergelaufene Toilette oder eingedrungenes Hochwasser hinterlassen oft mehr Schaden, als man zunächst sieht. Wasser und Schmutz setzen sich in Böden, Wänden und Fugen fest. Wir kümmern uns um die betroffenen Bereiche, sobald die Ursache behoben ist. Zuerst werden Flüssigkeiten entfernt, danach folgt die gründliche Reinigung der Flächen. Wenn nötig, schließen sich weitere Schritte an. Gerade bei Abwasser ist Vorsicht geboten. Deshalb wird mit entsprechender Schutzkleidung gearbeitet. Ziel ist es, die Räume wieder in einen ordentlichen Zustand zu bringen und weitere Schäden zu vermeiden. Vor Ort klären wir, was sinnvoll ist und welche Maßnahmen erforderlich sind. Jede Situation ist anders.
Boppert & Arndt
Reinigung nach Havarie

Schimmel zeigt sich oft zuerst in Ecken, an Fensterlaibungen oder hinter Möbeln. Manchmal bleibt er lange unbemerkt. Wenn er sichtbar wird, sollte man handeln. Wir schauen uns die betroffenen Stellen an und klären, wie weit sich der Befall ausgebreitet hat. Danach besprechen wir, was sinnvoll ist. In manchen Fällen reicht eine gezielte Reinigung. In anderen muss mehr gemacht werden. Gearbeitet wird mit passenden Mitteln und unter Schutzmaßnahmen. Wichtig ist, nicht nur die sichtbaren Spuren zu behandeln, sondern auch die Ursache im Blick zu behalten. Wenn zusätzliche Schritte nötig sind, etwa durch Handwerksarbeiten oder eine fachliche Einschätzung, wird das offen angesprochen. Für eine Besichtigung melden Sie sich einfach. Dann sehen wir weiter.
Boppert & Arndt
Schimmelentfernung
Wir sind regelmäßig für Spezialreinigungen in diesen Städten & Bundesländern im Einsatz und haben dort bereits zahlreiche Objekte gründlich und fachgerecht gereinigt:
Bayern
Baden-Württemberg
Spezialreinigung gesucht?
Dann Boppert & Arndt!
Zur Spezialreinigung zählen Arbeiten, die nicht alltäglich sind. Dazu gehören Tatortreinigung, Leichenfundortreinigung, Brandschadenreinigung, die Reinigung von Raucherwohnungen oder stark vernachlässigten Wohnungen sowie Maßnahmen bei Schimmel oder nach Wasserschäden.
Jeder Fall ist unterschiedlich. Manchmal reicht eine gründliche Reinigung, in anderen Situationen müssen einzelne Materialien entfernt werden. Was notwendig ist, wird vor Ort geprüft.
Gearbeitet wird mit geeigneter Schutzkleidung und unter Beachtung der geltenden Vorgaben. Wichtig ist ein sachliches Vorgehen und klare Absprachen.
Am Ende geht es darum, die betroffenen Räume wieder in einen ordentlichen Zustand zu bringen.
Sie lesen einen Artikel zum Thema: Spezialreinigung